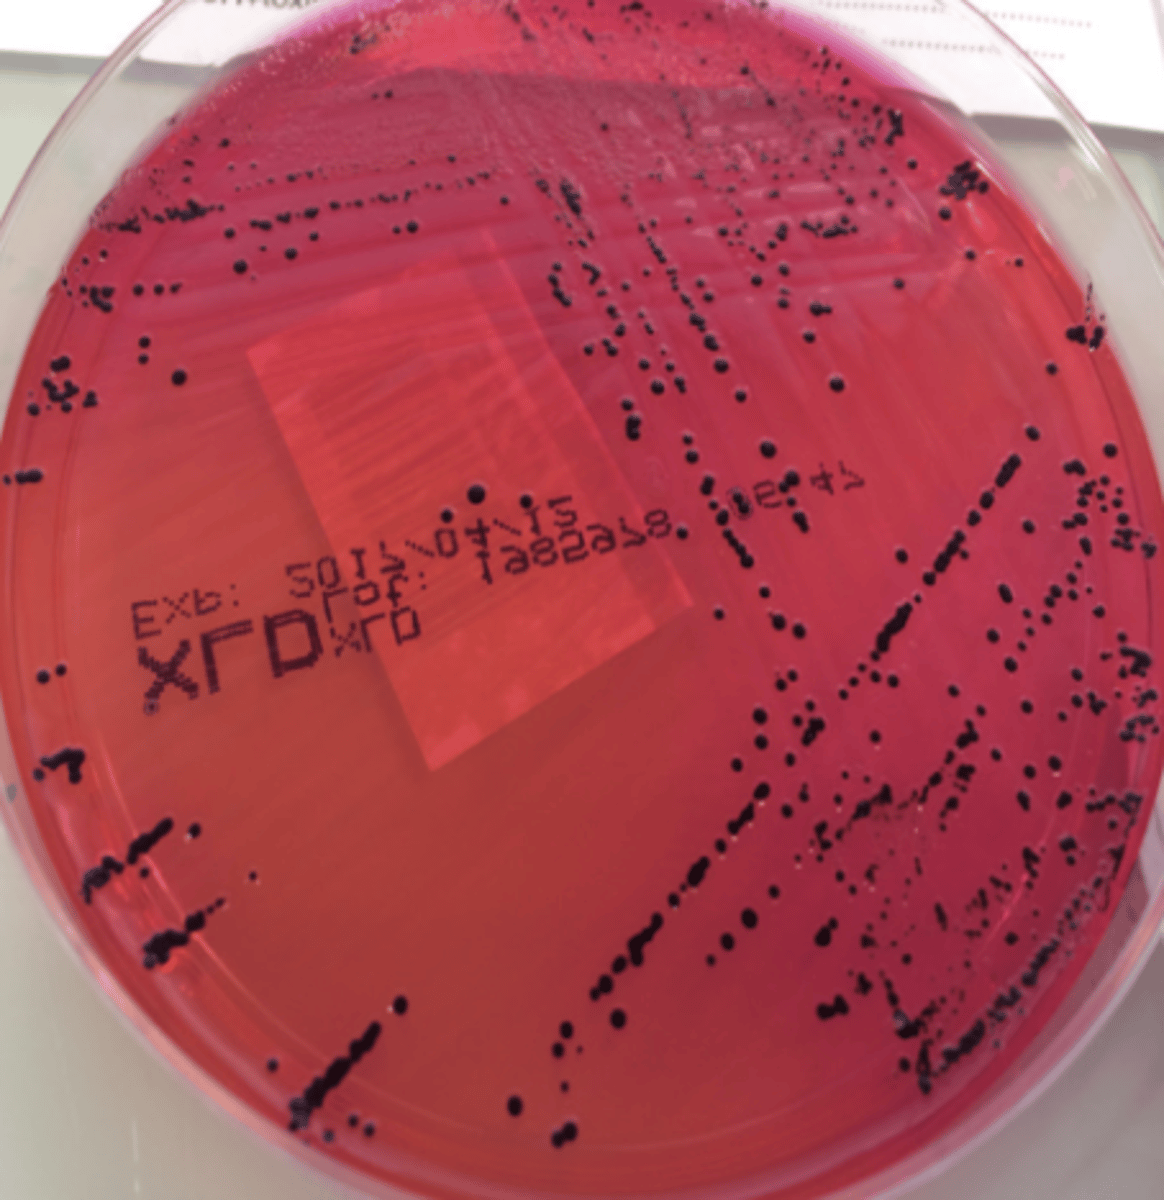
<p>Milieu : SS</p><p>Température : 37 degrés</p><p>Durée : 24h</p><p>Aspect : Translucides à centre noir </p>

1/19
Looks like no tags are added yet.
Name | Mastery | Learn | Test | Matching | Spaced | Call with Kai |
|---|
No analytics yet
Send a link to your students to track their progress
Quelle est la morphologie de la bactérie?
Bacille Gram -
Mobile
Non capsulée (parfois...)
Non sporulée
Famille : Entérobactéries

Donner les caractères biochimiques
Entérobactéries :
Oxydase -
Nitrate réductase +
Glucose +
Lactose -
H2S +
Quels sont les facteurs de virulence de la bactérie?
Endotoxine : LPS
Facteur d'adhésion et d'invasion : Pili, flagelle
Capsule : Ag Vi
Quelles infections provoque Salmonella enterica?
Infections du tube digestif
Salmonellose typhique : Fièvre typhoïde
Salmonella enterica typhi / paratyphi
Salmonellose non typhique : Gastro-entérite, TIAC
Salmonella enterica typhimurium / enteridis
Quelle est l'épidémiologie de la salmonellose typhique?
Quel est le réservoir de la bactérie?
Mode de transmission?
Maladie lié au péril fécal
Endémique : Afrique, Asie, Inde, Mayotte, Guyane
France : Rare, sporadique, cas d'exportation
Réservoir : Strictement humain
Transmission : Voie digestive féco-orale
DIRECTE : Interhumaine, manuportée
INDIRECTE : Eau, crudités, coquillage, fruits de mer, aliments souillés

Quelle est l'épidémiologie de la salmonellose non typhique?
Quel est le réservoir de la bactérie?
Mode de transmission?
Représente 40% des TIAC en France
Réservoir : Humain & animal : zoonose
Oiseaux, volailles, mammifères
Transmission :
Alimentaire : oeufs, lait, viandes crues, peu cuite
Rupture de la chaine du froid

Quelle est la physiopathologie de l'infection?
1. Invasion des cellules épithéliales intestinales
2. Pénétration des cellules M
3. Phagocytose par les macrophages
4. Ganglions mésentériques :
-> soit détruit
-> soit rejoint la circulation sanguine : bactériémie
Quelles sont les manifestations cliniques de la salmonellose typhique? Donner le temps d'incubation
T incubation : 1 à 3 semaines
INFECTIONS SYSTÉMIQUES
Phase d'invasion : Fièvre progressive atteignant 40 degrés, douleurs abdominales, constipation
Phase d'état : diarrhée en jus de melon, signe neuropsychique : tuphos, signe cutané
Quelles sont les manifestations cliniques de la salmonellose non typhique? Donner le temps d'incubation
T incubation : 12 à 24h
TIAC, diarrhée infectieuse
Fièvre > 38,5 degrés
Céphalée
Vomissement, douleur abdo diffuse
Syndrome dysentérique possible : ténesme, épreinte, glaire, sang dans les selles
Quel est le risque majeur d'une salmonellose?
Immunocompétent : Déshydratation
Immunodéprimé : bactériémie
Quels sont les facteurs de risque?
Voyage en zone endémique
Nourrisson, personnes âgées
Immunodéprimés
Décrire le diagnostic d'une salmonellose typhique
Symptômes : Fièvre à 40 degrés avec prostration, tuphos...
Prélèvement : Sang 🩸
Culture : Hémoculture
Identification : Spectrométrie de masse
Ac anti-Ag O et H (pas très contributif)
Antibiogramme : surtout si voyage Inde/Asie
Décrire le diagnostic d'une salmonellose non-typhique
Symptômes : Gastro-entérite
Prélèvement : Selles fraichement émise 💩
Culture : Coproculture
Identification : Spectrométrie de masse
PCR dans les selles
Quel est le traitement de la salmonellose typhique?
Formes non compliquées : Azithromycine
Remplacée par Ofloxacine / Ciprofloxacine après ATBiogramme
QSP 5 à 7 jours
Formes compliquées : Ceftriaxone IV
Remplacée par Ofloxacine / Ciprofloxacine après ATBiogramme
QSP 10 à 14 jours
Quel est le traitement de la salmonellose non typhique?
Réhydratation orale
Apport d'électrolytes
Sujets à risque : FE, dépranocytaire, vieux, < 1 an, immunodéprimé : ATB
Azithromycine QSP 3 à 7 jours
ou : Ciprofloxacine, Ceftriaxone IV
Quels sont les mesures de prévention?
- Hygiène des mains : lavage à l'eau savonneuse
- Hygiène alimentaire
- Vaccination pour les voyageurs en zone d'endémie
Est-ce qu'il existe un vaccin?
OUI : Typhim
Vaccin polysaccharidique inactivé
Recommandé chez les voyageurs en zone d'endémie
x1 injection IM
Protection pour environs 3 ans

Est-ce que la déclaration est obligatoire?
OUI
-> TIAC
-> Fièvre typhoïde
Donner les conditions de culture
Milieu : SS
Température : 37 degrés
Durée : 24h
Aspect : Translucides à centre noir
Quels sont les résistances de la bactérie?
Parfois aux FQ
D'où l'importance de faire un ATBiogramme avant de donner Ciprofloxacine / Ofloxacine